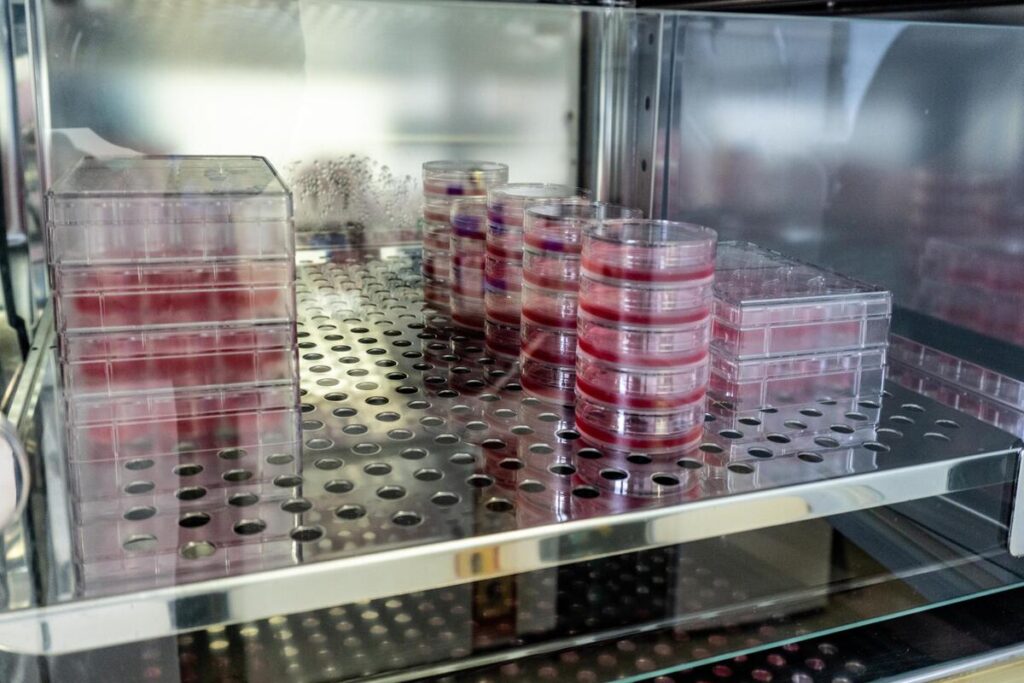
Лабораторные исследования

После её смерти учёные сделали эту женщину бессмертной. Но она никогда на это не соглашалась.

Память о Генриетте Лакс
В марте 2024 года Университет Таскиги открыл памятник Генриетте Лакс и её вкладу в борьбу с полиомиелитом. Всего несколькими днями позже завершился приём заявок на конкурс проекта памятника в её родном округе Халифакс, штат Вирджиния.
Неудивительно, что Лакс продолжают почитать спустя более чем 70 лет после её смерти. Ведь её «бессмертные» клетки HeLa сыграли решающую роль в разработке методов лечения таких болезней, как полиомиелит, ВИЧ/СПИД и COVID-19. Однако наследие Лакс остаётся противоречивым из-за этических вопросов, связанных с использованием её уникальных клеток.
Лакс умерла от рака в возрасте 31 года в 1951 году. Она так и не узнала, что её клетки привели к важнейшим медицинским открытиям — и что их взяли без её ведома. Даже сегодня её история вызывает споры о том, какими сомнительными методами человечество достигало неоспоримых прорывов в медицине.
Короткая жизнь и бессмертные клетки

Жизнь Генриетты Лакс была непростой и короткой. При этом её имя оставалось малоизвестным при жизни. Лишь после выхода книги Ребекки Склут «Бессмертная жизнь Генриетты Лакс» в 2010 году мир узнал её историю.
Благодаря трудам Склут и усилиям её потомков, которые через проекты вроде HeLa100 стремились рассказать миру правду, мы лучше понимаем, кем была женщина, которую называют «матерью современной медицины».
Генриетта родилась 1 августа 1920 года в Роаноке, штат Вирджиния. Когда в 1924 году умерла её мать, девочку отправили жить к дедушке в бревенчатый домик на бывшей плантации. Там же жил её двоюродный брат Дэвид «Дей» Лакс. В 14 лет Генриетта родила их первого ребёнка, Лоуренса, в 1941 году они поженились. В 1939 году у них родилась вторая дочь Элси, а позже семья пополнилась ещё тремя детьми: Дэвидом-младшим, Деборой и Джо.
Болезнь и роковой диагноз
1 февраля 1951 года Генриетта пришла в больницу Джонса Хопкинса в Балтиморе. У неё были сильные боли и кровотечения внизу живота. В то время это было одно из немногих медицинских учреждений, где лечили бедных афроамериканцев.
Врач Говард Джонс быстро поставил диагноз — рак шейки матки. Женщине назначили лечение с помощью радия. Но без её согласия врачи взяли два образца тканей. Лечение не помогло. 8 августа Лакс снова оказалась в больнице, а 4 октября 1951 года она умерла. Похоронили её в безымянной могиле в Кловере, Вирджиния, где прошли её ранние годы.
Рождение бессмертных клеток

Генриетта не знала, что её образцы передали в лабораторию известного онколога Джорджа Отто Гея. Учёный собирал клетки у всех пациентов с раком шейки матки, независимо от их происхождения и достатка. Но обычно такие клетки погибали через несколько дней. Удивительно, но клетки Генриетты удваивались каждые 20–24 часа.
Это открытие перевернуло медицину. Гей выделил и размножил клетки, создав клеточную линию. Он назвал её HeLa — по первым буквам имени и фамилии женщины. Эти клетки помогли Джонасу Солку создать вакцину против полиомиелита, что вызвало огромный интерес к ним. Уже в 1955 году учёные научились клонировать клетки.
С тех пор с использованием HeLa зарегистрировали более 10 000 патентов. Эти клетки применяли для изучения болезней, тестирования лекарств и даже для разработки вакцин против COVID-19.
Однако семья Лакс узнала правду только спустя почти 20 лет. Всё это время СМИ приписывали происхождение клеток вымышленным «Хелен Лейн» или «Хелен Ларсон».
Этические вопросы и замалчивание
В 2010 году больница Джонса Хопкинса заявила: в середине XX века практики получения согласия на использование тканей просто не существовало. Никто не спрашивал разрешения пациентов.
Но исследование Ребекки Склут показало, что у Генриетты брали образцы и после её смерти. По закону врачи обязаны были спросить разрешение мужа на вскрытие. Сначала он отказался, но позже согласился, поверив обещаниям, что результаты помогут детям. Этих результатов семья так и не увидела.
Сам университет утверждает, что никогда не извлекал прибыль из HeLa-клеток, а лишь бесплатно делился ими с исследователями. Но многие компании зарабатывали на этом. В 2023 году корпорация Thermo Fisher Scientific даже заключила мировое соглашение с семьёй Лакс, признав коммерческое использование клеточной линии.
Как менялись медицинские стандарты

История Лакс тесно связана с развитием медицинской этики в США. В первой половине XX века популярностью пользовались идеи евгеники. Их поддерживали даже известные учёные и общественные деятели.
После Второй мировой войны суды в Нюрнберге раскрыли ужасы нацистских экспериментов. Это привело к созданию Нюрнбергского кодекса, который впервые сделал добровольное согласие обязательным условием для исследований. Но в США этот кодекс сразу не приняли, а параллели с собственной практикой, включая случай Лакс, заметили не сразу.
В 1966 году доктор Генри Бичер опубликовал статью «Этика и клинические исследования». Он разоблачил 22 примера экспериментов над пациентами без их ведома. Среди них были случаи, когда людям вводили живые раковые клетки или вместо лечения давали плацебо.
Эта публикация потрясла общество. Ведь речь шла не о нацистских врачах, а о уважаемых американских учёных. Позже статья Бичера стала основой для первых официальных правил NIH и FDA.
Память о Генриетте Лакс
Сегодня о Генриетте Лакс чаще всего говорят через призму научных открытий, которые стали возможны благодаря её клеткам. Но сам Бичер ещё полвека назад писал: эксперимент этичен только в момент его начала, а не постфактум. Никакая цель не оправдывает средства.
Невозможно сказать, дала бы Генриетта согласие на использование своих клеток, если бы знала, какие открытия они принесут. Но теперь мы точно знаем: её клетки изменили медицину навсегда. И хотя многие пытались скрыть их происхождение, имя Генриетты Лакс стало бессмертным. Вопрос лишь в том, что её бессмертие должно было быть её выбором. Если бы только кто-то тогда спросил.





